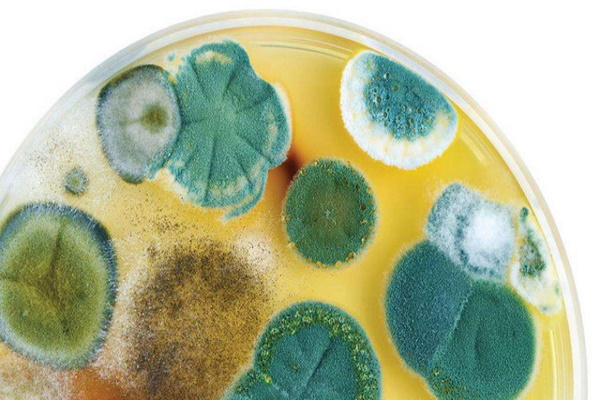
Как избавиться от запаха плесени?

Лента новостей
Ambassadori Island может изменить расстановку сил на рынке недвижимости Батуми
ARTPLAY запускает конкурс скульпторов для интерактивной выставки на террасе центра
«Опора России» просит Путина защитить единство рынка от региональных запретов вейпов
«Вертолеты России» представили импортозамещенный Ми-171А3 на ЭКСПО в Харбине
Общество
Как избавиться от запаха плесени?
Мы стараемся поддерживать комфортный микроклимат в доме, вовремя избавляться от пыли, находить баланс между сухостью и влажностью воздуха, но, несмотря на все усилия, на стенах ванной комнаты может появиться чёрный грибок, а в шкафу стоит затхлый «аромат».
Запах плесени в квартире может появиться буквально за ночь, особенно в сезоны, когда стоит сырая и влажная погоды. Избавление от этого запаха требует постоянных усилий, и быстрого решения здесь нет. В «Интернете» Вы найдёте множество лайфхаков о том, как избавиться от запаха плесени, как почистить стену от грибка, как устранять неприятные затхлые ароматы в салоне автомобиля или в баке стиральной машины, но на практике убедитесь, что большинство из них трудозатратны и при этом малоэффективны, а, главное, ни один из способов не решает проблему навсегда.
Борьба с плесенью и затхлостью – это постоянный процесс, поэтому важно выбрать правильную стратегию и тактику, выработать эффективные методы и включить их в регулярную и генеральную уборки.
Одним из основных источников запаха плесени часто оказывается мягкая мебель. Комфортные глубокие кресла и уютные диваны, особенно с ворсовым покрытием, нуждаются в частой чистке: поверхность нужно избавить от пыли, обработать набивку, чтобы препятствовать разрастанию спор. Древний домашний метод – застелить поверхность влажной тряпкой и выбить палкой – бывает сложно реализовать в условиях мегаполиса, химчистка мягкой мебели в Москве – один из самых современных и рациональных способов. Химчистка – это многоэтапный процесс обработки, когда диваны, пуфики и кресла избавляют от пыли, пятен, потёртостей, спор и продуктов жизнедеятельности разнообразных микроорганизмов.
Причиной появления плесени и сопутствующего запаха считается сырость, поэтому важно найти и устранить источник этой сырости. Иногда таким оказывается именно диван, на который дети по неосторожности пролили напиток. В таких случаях важно не только просушить мебель, но и убрать остатки жидкости.
Эпицентром распространения плесени могут быть не только случайные, но и постоянные источники: ванная комната, внутренний блок кондиционера, увлажнитель воздуха, умные горшки для комнатных растений с автоматической системой полива, аквариумы. Устранить эти источники не всегда возможно, и приходится бороться с последствиями: вовремя менять фильтр кондиционера, просушивать и обрабатывать санузел, следить за чистотой аквариума и так далее.
Важно регулярно проветривать все комнаты в квартире или доме, открывать шторы или жалюзи, чтобы в помещения проникал солнечный свет. Затхлый запах появляется из-за застоя воздуха, причиной которого может оказаться неправильно организованная система вентиляции – в результате плесень из подвала оказывается в жилых помещениях. В многоквартирных домах причиной плесени могут быть соседние квартиры, если их жильцы неаккуратно обращаются с водой или пренебрегают уборкой. Но и в таких обстоятельствах с причинами неприятных запахов можно эффективно бороться – для этого нужно регулярно проводить гигиеническую обработку в собственной квартире.
